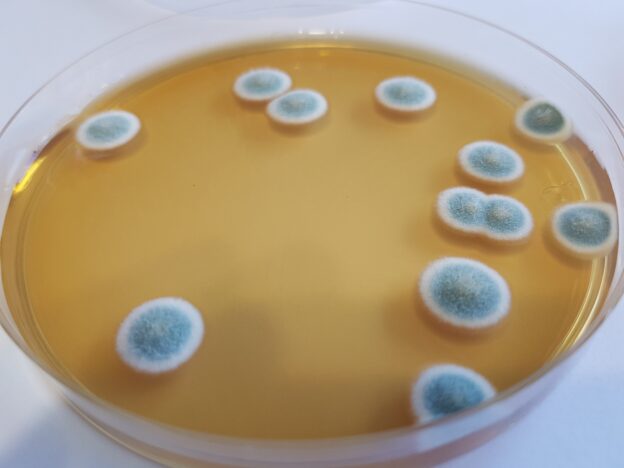

MALT EXTRACT CLORANFENICOL AGAR es un agar al extracto de malta para detección y recuento selectivo de hongos (levaduras y mohos)
COMPOSICIÓN
- Extracto de malta 30 g
- Peptona de Soja 3 g
- Cloranfenicol 0,1 g
- Agar agar 15 g
(Fórmula por litro)
pH final: 5,4 ± 0,2 tras ajustarlo con ácido láctico
PREPARACIÓN
Disolver 48,1 g en 1 litro de agua destilada. Calentar agitando hasta ebullición. Autoclavar a 121ºC durante 15 minutos (o mejor aún, 116 °C, 15 minutos).
El cloranfenicol inhibe el crecimiento de bacterias, pero para un óptimo crecimiento fúngico, enfriar a 55°C tras autoclavar y acidificar con Ácido Láctico estéril al 10% (SAJ003). No recalentar el medio. Se puede añadir 1 ml/l de glicerol (SDA073) para evitar el desecamiento de placas con cultivos lentos.
PARA USO EXCLUSIVO EN LABORATORIO MANTENGA EL BOTE BIEN CERRADO EN LUGAR SECO, FRESCO Y OSCURO. AGITE EL BOTE ANTES DE USAR.
DESHIDRATADO CODIGO: DMT221
CONTROL DE CALIDAD DEL MEDIO
Realizado en nuestro laboratorio; es prudente repetirlo en su laboratorio siempre que varíen las condiciones (más de 3 meses sin usar, tras desinfectar laboratorio, tras conservar a alta Tª, cuando adquiere aspectos extraños aunque no haya llegado la fecha de caducidad teórica de la etiqueta,…)
DESHIDRATADO: Polvo fino, Tostado
PREPARADO: Estéril, Ámbar
CONTROL DE CRECIMIENTO 3-5 días a temperatura ambiente (21-28°C aproximadamente):
- Aspergillus niger MKTA 16404, Correcto, Colonias negras y esporuladas en 5 días. Con respecto a PCA standarizado*, recuento 129 %, pero de forma selectiva.
- Candida albicans MKTA 10231, Correcto. Con respecto a PCA standarizado*, recuento 83 %, pero de forma selectiva.
- Saccharomyces cerevisiae MKTA 9763, Correcto. Con respecto a PCA standarizado*, recuento 109 %, pero de forma selectiva.
- Staphylococcus aureus MKTA 6538P, Inhibido.
- E.coli MKTA 25922, Inhibido.
* El que cumple con recuperación superior al 92-125% con respecto a cepas cuantitativas trazables a la cepa tipo.
PRESENTACIÓN: MEDIO DESHIDRATADO
MODO DE EMPLEO E INTERPRETACIÓN DE RESULTADOS
Agite bien la muestra segundos antes de la siembra. Inocular 0,1 ml de muestra y su serie de diluciones decimales, en superficie, repartiendo con triángulo de vidrio (VRR154) o asas desechables de Digralsky (VCL155). Incubar 3-5 días a 21-25ºC aproximadamente. Contar las colonias no filamentosas de levaduras y filamentosas de mohos.
https://www.microkit.es/fichas/MALT-EXTRACT-CAF-AGAR.pdf
El usuario final es el único responsable de eliminar los microorganismos de acuerdo con la legislación medioambiental vigente. Autoclavar antes de desechar a la basura.
Si desea más información sobre nuestros MALT EXTRACT CLORANFENICOL AGAR, rellene nuestro formulario de contacto http://www.medioscultivo.com/contacto . O si lo prefiere póngase en contacto con nosotros a través de nuestro correo electrónico microkit@microkit.es o por teléfono en el nº 91-897 46 16